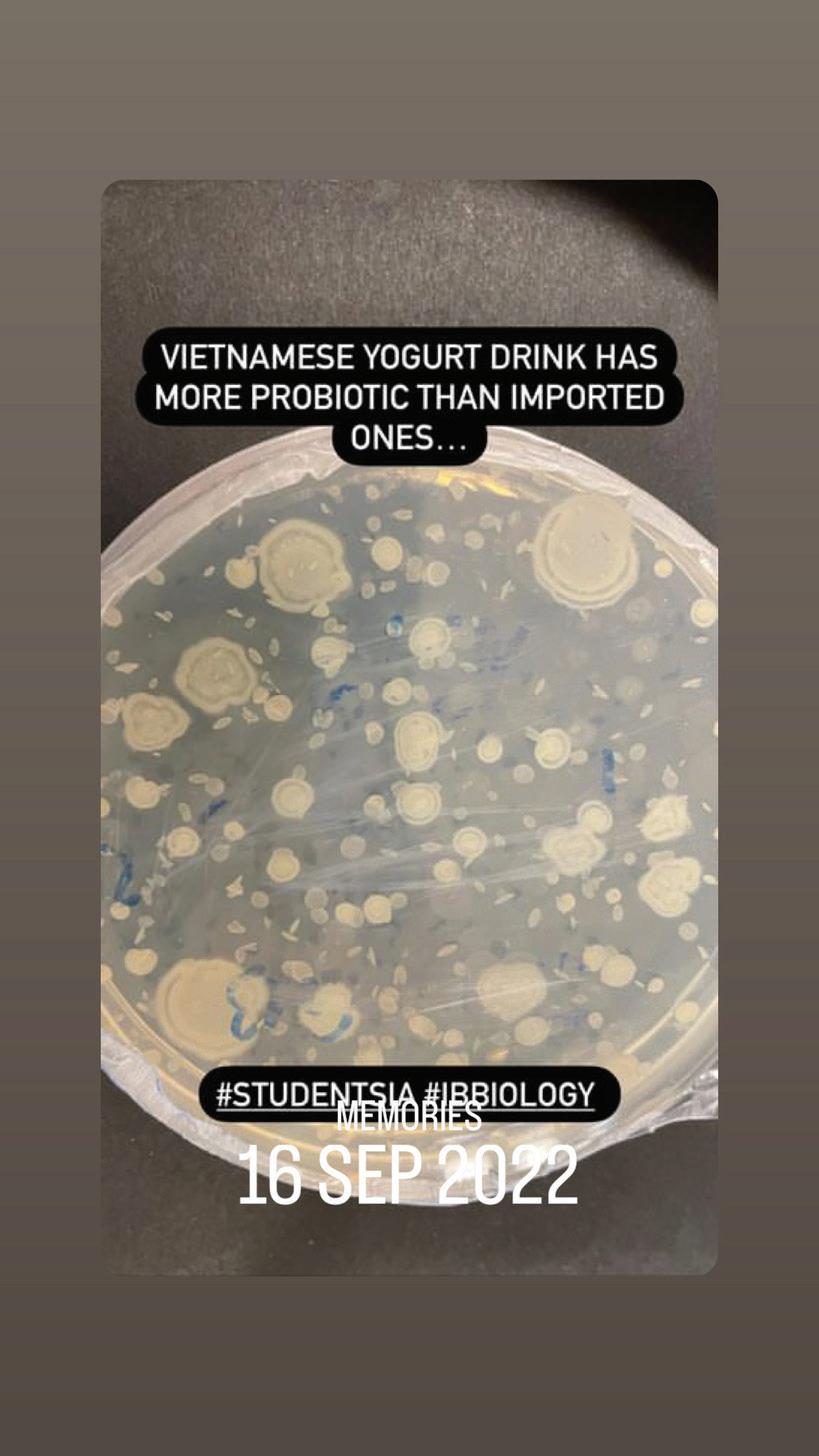

2022-2023
Message from the Acting Headmaster

Message from the Education Director













Message from Head of Preparatory
Message from Head of Secondary
Founder and Chair
Board of Management

Academic
Preparatory
Academic
school teachers Academic
Secondary
Academic
Teaching
Non-Academic staff Preparatory Classes Secondary Classes Preparatpry Homerooms Secondary Homerooms Teams ECAs Events Specialist Subject Areas Camps 1 2 3 4 5 5 6 7 8 10 11 15 35 71 83 103 109 111 133 165
staff -
teachers
staff - Whole
staff -
teachers
staff -
assistants
TABLE OF CONTENTS
MESSAGE FROM THE ACTING HEADMEASTER
HOPEFULLY THIS YEARBOOK WILL BE SOMETHING TO TREASURE AND LOOK BACK AT WITH FONDNESS IN YEARS TO COME. IN THE WORDS OF L.M MONTGOMERY: “NOTHING IS EVER REALLY LOST TO US AS LONG AS WE REMEMBER IT.”
Awarm welcome to the 2022-23 RGSV yearbook. This edition will go down in history as our first yearbook to bear the Reigate name. A big thank you to Mr Rob and his team for organising the process and guiding us throughout. As I write this, the yearbook is still being constructed, however I know that it will be packed with great photos, fantastic articles, celebrations of success and above all terrific memories that we can all look back on in years to come.
There have been so many wonderful events and terrific achievements since August that it is difficult to pick my favourites, but I look back on International Day, when we celebrated all the different nationalities represented in our school and I recall the tasty food, much of which was provided by our PTA. I think about my first experience of the Tet celebration and how lucky we were with the hot weather. The many sporting events that I have seen (swimming, football, cross country, basketball), where RGSV Primary and Secondary students competed with pride and determination. The Maths Olympiad, where one of our senior teams took the gold medals. The IB Diploma Programme Art exhibition was a great occasion and one where our musicians made a contribution, as they have throughout the year. The student leadership bodies have made a significant contribution.
I have been impressed with the maturity of the Senior Prefects who have set a good example to the rest of the school and helped out at our events, as well as being proactive in collaborating with RGSUK to initiate a charity event. We say goodbye to the Year 13 students who graduate this year and we wish them all the best for the future, together with some staff, who are moving to pastures new. Hopefully this Yearbook will be something to treasure and look back at with fondness in years to come. In the words of L.M Montgomery: “Nothing is ever really lost to us as long as we remember it.”
Mr Patrick Acting Headmaster

REIGATE GRAMMAR SCHOOL VIETNAM 1
MESSAGE FROM EDUCATION DIRECTOR
IT HAS BEEN A PRIVILEGE TO BE YOUR EDUCATION DIRECTOR, THANK YOU FOR MAKING IT SO SPECIAL. YOU HAVE ACHIEVED SO MUCH AND DESERVE TO BE.
Dear RGSV Pupils,
What an incredible year it has been! When I think back to my first visit to RGSV in April 2022 I can see how much has changed. The whole RGSV community has come together, building friendships and creating memories that will last a lifetime.
The end of a year is a time for reflection, to see how far we have come. Thinking back to the focus I shared with you at the start of the year, I think we can all be very proud of our successes:
• To bring the community back together and to reconnect
• To be kind to each other, to ensure everyone feels that they belong
• To gather student voice, as this is key to making improvementsto the school
• To create more connections across the year groups

As Reigatians, this is all part of being on a journey with a special purpose, to be good people. We have had so many wonderful community events that have given us the opportunity to reconnect, such as the brilliantly run student-led Mid Autumn festival full of activities from making Moon cake and Songpyeon to creating lanterns and paper masks, the joyful International Day celebrating our amazing diverse RGSV community of over 30 nationalities and the outstanding Festival of Light. We connected through sharing and learning about each other’s cultures and backgrounds. We are proud to be inclusive of everyone, part of the global RGS family, and value the richness that it adds to our school days.
Ensuring everyone feels valued and supported is central to all that we do here at RGSV and is behind all of the decisions we make. Our Year 7 Empathy project, where we collaborated with RGS UK, is a great example of our pupils working together, sharing experiences and helping each other to gain a deeper understanding of different backgrounds and cultures. Another great example of working together as an RGS family was the RGS UK Gap students visit; George and Conor gained so much by their time here, and our pupils greatly valued their contributions. This pilot project was such a success we are looking to repeat this in the years to come.
It has been a privilege to be your Education Director, thank you for making it so special. You have achieved so much and deserve to be.
With my very best wishes,
Ms Arabella
YEARBOOK 2022-2023 2
MESSAGE FROM THE HEAD OF PREPARATORY








IT HAS BEEN A PLEASURE TO BE YOUR HEAD OF PREPARATORY THIS YEAR: A YEAR YOU CAN ALL BE REALLY PROUD OF, AND I WISH ALL OF YOU THE VERY BEST FOR YOUR FUTURES!
Dear Preparatory Pupils,
Welcome to the Preparatory School’s Yearbook Section. I hope and encourage you to enjoy looking back through this collection of photos, achievements and memories of our school year together. May I also take this opportunity to thank Mr Rob and his team for putting together such a fantastic yearbook!
When I think about all you have accomplished this year my head starts to hurt! You have all had a superb year. Whenever I walk into classrooms, I can hear the buzz of learning, of excited and hard-working children and of kindness, laughter and fun. I hope you all remember that learning should involve that: fun! I am, in fact, reminded of a quote by the civil-rights activist and poet, Maya Angelou: ‘Try to be a rainbow in someone’s clouds’. I think we have a lot of rainbows!
I have been impressed by the quality of your work in the classroom, your presentation and performance skills in assemblies and your enthusiasm in sport. We have had brilliant festivals, a super Sports Day and Swim Gala, Book Week, art exhibitions, musical performances, Pupil Led Conferences and an amazing PYP Exhibition. There have been some brilliant trips out (my personal highlight being the Year 6 Camp!), fantastic community events such as International Day, our Lunar and Winter Festivals, sports competitions and there have been lots of friendships made.
It has been a pleasure to be your Head of Preparatory this year: a year you can all be really proud of, and I wish all of you the very best for your futures!
Best wishes,
 Mr Simon
Mr Simon

3
REIGATE GRAMMAR SCHOOL VIETNAM
MESSAGE FROM THE HEAD OF SECONDARY

THE LATE WALT DISNEY ONCE SAID, “IF YOU CAN DREAM IT, YOU CAN DO IT.” WELL, YOU CAME, YOU DREAMED, YOU BELIEVED AND YOU ACHIEVED. WELL DONE!
Dear Secondary School students,
This has been our first full year as Reigate Grammar School Vietnam, and a full year of on-Campus Learning and Teaching. I welcome you to, and encourage you to enjoy, the pages dedicated to our Secondary School in this edition of the Yearbook.
I thank Mr. Rob and his team, as well as all involved in the Secondary, for collating our memories and achievements over this year. As you can see they have done a fantastic job.
Once again, you, the students of our Secondary School have shown your development and growth and should be proud of your achievements. The great year we have had was created by the contributions of each and everyone one of you.
Looking smart (most of you! most of the time!) in your new uniforms, you have represented yourselves and the School in many activities and events. Our sports teams have returned with some great sporting seasons and results, and rebuilt the essential team spirit of the Panthers and Orcas. Our debaters, thinkers, and speakers have excelled in World Scholars’ Cup, MUN, TEDx and PYN events both in and out of School. Our Artists and Musicians have shined in demonstrating their talents in exhibitions and performances. All students have shown their risk-taking and team-building attributes on our School camps and their celebration of our community with events such as International Day, mid-Autumn festival, Lunar Festival and Winter Bazaar.
The late Walt Disney once said, “If you can dream it, you can do it.” Well, you came, you dreamed, you believed and you achieved. Well done!
Feliz verano!
Mr Colin
4
YEARBOOK 2022-2023
FOUNDER AND CHAIR

BOARD OF MANAGEMENT













5
Thuy Mai Founder & Chair of RGS Vietnam
Patrick Glennon Acting Headmaster
Simon Sharp Head of Preparatory
Colin Bradshaw Bastida Head of Secondary
Arabella Crook Education Director
Ly Tran Managing Director
REIGATE GRAMMAR SCHOOL VIETNAM
Hoang Doan Admissions Director
ACADEMIC STAFF PREPARATORY TEACHERS


































6
Amy RYCKAERT PYP Classroom Teacher
Deirdre MCCABE PYP French Teacher
Denis MOLONEY PYP Classroom Teacher
Talia SETTY Key Stage I Teacher
Kezia CAPULONG PYP Language Coordinator
Isabelle GERONA PYP EAL Teacher
Judith MOCLAIR PYP Classroom Teacher
Katie ASHCROFT PYP Classroom Teacher
Nikki FARRAR PYP Classroom Teacher
Kristopher REDMOND PYP Classroom Teacher
Samantha KRUEGER PYP Classroom Teacher
MA. Jessanin Dela ROSA PYP Music Teacher
Tiffany GILLILAND PYP Classroom Teacher
Yee Young YUN Korean Teacher
YEARBOOK 2022-2023
Van Anh HO Vietnamese Language Teacher
Ngan Quynh NGUYEN Vietnamese Language Teacher
Katy GAWNE Primary Teacher
ACADEMIC STAFF WHOLE SCHOOL TEACHERS




























7
Geoffrey DICKINSON Librarian Teacher/ EE Coordinator
Daniel HEWITT Head of Music
Elizabeth SCHULZE Head of Visual Arts
Hayden SCHULZE Head of PE
Gemma SCOTT PE Teacher/ Pastoral Leader
Juan Alberto Soler GARCIA Sport Coach
Sarah ADAM Art Teacher
Manuel HERNANDEZ Music Teacher
REIGATE GRAMMAR SCHOOL VIETNAM
Madonna RAMIREZ PE Teacher
ACADEMIC STAFF SECONDARY TEACHERS








































8
Anita WIJAYA Director of Studies
Gita GEMUTE DP Coordinator
Richard CROOK Cambridge Coordinator
Jazmyn RIMINGTON Head of English
Ian STUCKEY Head of Computing
Sandra GERRITS Head of Humanities
Simon EARDLEY Head of EAL
Sonali DIXIT Head of Science
Hien Thu Thi PHAN Head of Vietnamese
Thierry JESTIN Head of Language Acquisition
Aaron MAYO University Counsellor
David CROFT Humanities/History Teacher
Edward FORWARD IBDP TOK Coordinator
Jason CORDRAY Secondary English Teacher
James HOPKINSON Humanities/ Geography Teacher
Joseph MARQUEZ Mathematics Teacher Kendall QUISENBERRY English Teacher
Lisa de RENZY-MARTIN English Teacher
Ludwine de JONGH EAL Teacher
YEARBOOK 2022-2023
Ludovic PIROLLEY French Teacher
ACADEMIC STAFF SECONDARY TEACHERS






















9
Manrik THIARA Mathematics Teacher
Huiyen ONG Science/ Biology Teacher
Preston DUKES EAL Teacher
Robert MOORS IT Teacher
Redhemer PAYAD Computer Science Teacher
Sander ter MEULEN Science/ Biology Teacher
Sang Hoon SEO Korean Teacher
Will HARASTA Humanities Teacher
Andrew SILVANUS Science Teacher
Binh Thi LINH Vietnamese Language Teacher
REIGATE GRAMMAR SCHOOL VIETNAM
Hien Thu Thi NGUYEN Vietnamese Language Teacher
ACADEMIC STAFF TEACHING ASSISTANTS











































10
Chien Thi DO Yen Thi PHAM Anh Thi TRU
Nga Thi VU Anh Phuong PHAN
Yen Thu NGUYEN Hoa Minh Thi TRAN Lien Thi DUONG Lab Technician
Hao Thanh Thi HOANG PE Teaching Assistant
Ngoc Minh TRAN Lab Technician
Chung Van HOANG PE Teaching Assistant
Yen Hai CHU Lab Technician
Hong Thu NGUYEN Art Assistant
YEARBOOK 2022-2023
Hoang Nhat NGUYEN Lab Technician
NON-ACADEMIC STAFF


















































11
Hong Thu Thi HOANG Secondary Office Manager
Hang Thanh HA Secondary Office Assistant
Quynh Nhu HOANG Secondary Office Assistant
Chi Hanh NGUYEN Preparatory Office Manager
Van Thao TRAN University Counseling Assistant
Anh Dieu NGUYEN Prep Office Assistant
Duong Ha VU Prep Office Assistant
Giang Nam Ha LUONG Education Director Assistant
Nhan Hanh Thi HOANG Library Assistant
Diep Hong DANG Library Manager
Diep Ngoc Thi NGUYEN Registrar Manager
Anh Phuong NGO Registrar Officer
Linh Thuy BUI Chief Accountant
Huyen Thi NGUYEN Accountant
Huong Vuong LE Accountant
Hien Thi NGO Accountant Toan Manh TRAN Admin Manager
Anh Huy NGUYEN Admin Assistant
Linh Ngoc Thi TRAN HR Officer
REIGATE GRAMMAR SCHOOL VIETNAM
Hao Thi HOANG HR Officer
NON-ACADEMIC STAFF









































12
Tien Van NGUYEN IT Manager
Quang Huu VU IT Deputy Manager
Ly Duy NONG Admissions Officer
An Thuy MAI Admissions Executive
Anh Minh NGUYEN Communications Manager
Anh Phuong PHAM Communications Officer
Chi Linh Phan VU Communications Officer
Nam Ho LE Facilities Manager Tai Dang NGUYEN M&E Team Supervisor
Binh Thanh TRAN M&E Officer
Phong Tien LE M&E Officer
Thuy Van LE Cleaning team Manager
Oanh Kim Thi PHAM Cleaning team Deputy Manager
Thanh Mai Thi LE Team Leader
Lai Thi LE Housekeeper Quynh Thuy Thi PHAM Housekeeper
Du Thi NGUYEN Housekeeper Lan Ngoc Thi DINH Housekeeper
YEARBOOK 2022-2023
Le Thi PHAM Housekeeper
Jin Yeong KANG Korean Liaison Officer
NON-ACADEMIC STAFF




















13
Trang Thanh LE Housekeeper An LA Housekeeper
Loan Hong Thi NGUYEN Housekeeper
Dung Trong NGUYEN Housekeeper
Truong Van PHAM Team Leader
Trang Cong DINH Housekeeper
REIGATE GRAMMAR SCHOOL VIETNAM
Khuong Viet NGUYEN Housekeeper An Viet NGUYEN Housekeeper
Ly Thi HOANG Housekeeper
Chien Van NGUYEN Housekeeper











14
NURSERY - RECEPTION















































15
Quan Minh BUI Tri Quoc VU Ngoc Minh PHAN
Vy REDMOND Duc Minh PHAN (David)
Sophia Nenita CROFT
Anh Duc NGUYEN Tung Hoang TRAN
Ms. Tiffany GILLILAND
Ms. Chien Thi DO
Anh Tu HOANG Binh Phuong VU Dat Tien PHAM
Isabelle Grace PEARMAIN
REIGATE GRAMMAR SCHOOL VIETNAM
Omar Mohammed I. DAHLWY
Khoa Dang Tran PHAN


16
The expert in anything was once a beginner. Helen Hayes
YEAR 1




















17
Anh Nhat NGUYEN Seoyoung KIM Sia PARK
Zane Aero PAYAD
Khue Minh NGUYEN
Khoi Minh HOANG Yewon AN Minjun KIM
REIGATE GRAMMAR SCHOOL VIETNAM
Mr. Kristopher REDMOND Ms. Anh Thi TRU
The beautiful thing about learning is that no one can take it away from you


18
B.B. King
YEAR 2




























19
SeoHyun PARK
Geonho CHOI
Bao Duc VU Yoonwoo JO (Aiden)
Riwon KIM
Riwon KIM (Ria)
Daechi CHOI (Max) Anh Chau TO (Cherry)
Linh Ja NGUYEN (Mon) Anh Nhat Nguyen HUYNH
George PEARMAIN Soohyun HONG
REIGATE GRAMMAR SCHOOL VIETNAM
Ms. Talia SETTY
Ms. Nga Thi VU
Education is the most powerful weapon you can use to change the world. B.B. King


20
YEAR 2










































21
Isobel Margaret COQUILLA
Phat Tien PHAM Jiho LEE
An Thai PHAN Ji Yoo CHOI (Julie)
Kaison Lee CHUMLEY
Eunsung LEE Minh Hieu NGUYEN
Taewoong AN
Hajun SHIN Jaeha PARK
Sihyun PARK
Ms. Isabelle GERONA Ms. Nga Thi VU
REIGATE GRAMMAR SCHOOL VIETNAM
Linh Gia TRAN
Caitriona May O’HARA
The mind is not a vessel to be filled but a fire to be ignited. Plutarch


22
YEAR 3




































































23
SeoWoo LEE
Huyen Khanh NGUYEN
Aayan Bolslaw PRADHAN
Oscar HERNANDEZ SILVA
Zayan Abid SAYED
Kien Jamie STUCKEY Anh Quynh PHAM
Vy Phuong DO Anh Thai NGUYEN Anh Do KIEU (Bau)
GeonHong LEE
Seojun LEE Kangjun CHOI (Stefan)
Koffi Wisdom KPESSE Zeal Cyan PAYAD Dong Wook KIM
Valeria RESTREPO
Sieun PARK Seyeon CHEON Minh Binh HOANG
Dan Linh LE Seo Jin KIM
REIGATE GRAMMAR SCHOOL VIETNAM
Ms. Katie ASHCROFT Ms. Yen Thi PHAM
Don’t let what you cannot do interfere with what you can do.

 John Wooden
John Wooden
24































































25
YEAR 4
Minje SUNG Dung Tien PHAM Uiseo JUNG Leah CHOI
Hanbyn KIM Julia MARCON LEE Seung Woo YU Geon Vin CHOI
Anh Nhat NGUYEN Eunho KIM
JiYu PARK Haedam NA Jack MURPHY
Jaya Gem GIM Bach Hoang NGUYEN Kien Quoc VU
Samuel James FARRAR Flynn William FARRAR
Lam Hoang DO
Sara Mohammed I. DAHLWY
Yoodan SHIN Ayeong CHOI
REIGATE GRAMMAR SCHOOL VIETNAM
Ms. Amy RYCKAERT Ms. Anh Phuong PHAN
A person who never made a mistake never tried anything new.
 Albert Einstein
Albert Einstein

26
YEAR 5


























27
Hyun Seo SO
Nam Bao NGUYEN (Tommy) Seo Eun JUNG (Sunny)
Leonardo CARRILLO ZEPEDA (Leo) Jun Seo YANG
Yoon Woo OH
Tae Hun LEE
Mercedes Le SCHOEN Lam Tuan DANG
Mai Phuong Joanna STUCKEY Dan Linh TRAN Bach Hoang TRAN
REIGATE GRAMMAR SCHOOL VIETNAM
Ms. Nikki FARRAR
Procrastination makes easy things hard and hard things harder.


28
Mason Cooley
YEAR 5































29
Serafima RADIONYCHEVA (Sima)
Yeonseo OH (Lucy)
Patricio GÓMEZ TAGLE RAMÍREZ
Tri Duc NGUYEN (Ben)
Tain Stone GIM
Yoonha KIL
Haeyun JUNG
YoonJe YOU
Lan Ngoc Nu PHAN (Sophie)
Aditya Bazyli PRADHAN
Suha PARK Soohwan BAE
REIGATE GRAMMAR SCHOOL VIETNAM
Mr. Denis MOLONEY
You don’t have to be great to start, but you have to start to be great. Zig Ziglar


30
YEAR 6









































31
Aditya MISHRA Gyeong Hu KIM
Thanh Hai DOAN
Thanh Dan Ngoc PHAM
Joon Young YU
Ji Wan LIM
Thomas Minh O’HARA
Binh An NGO
Han Gia Ha NGUYEN Rokgi YOON
Phong Hai NGUYEN (Alan)
Mattia Andres MARENACI Trang Hien Thi DUONG
Ms. Samantha KRUEGER
Ms. Yen Thu NGUYEN
Soomin HONG
REIGATE GRAMMAR SCHOOL VIETNAM
Linh Uyen NGUYEN
The biggest adventure you can take is to live the life of your dreams.
 Oprah Winfrey
Oprah Winfrey

32














































33
YEAR 6
Ms. Judith MOCLAIR Ms. Yen Thu Nguyen Yeon Woo JEONG
Thang Quoc DO Dung Trung NGUYEN
Jola Gray Darling GIBB
Yoon Seo KIL Oscar Le THIBERT
Araina GUPTA
Theresa Ha Linh EARDLEY
Aryan DHAKA Chai Eun SUNG Tri Dai Tran LE Dong An Vu TRAN Thuy Ngoc TRAN (Ylang)
REIGATE GRAMMAR SCHOOL VIETNAM
Minh Quang TRUONG Dong Geon KIM Yoonseong CHOI
The way to get started is to quit talking and begin doing.


34
Walt Disney
YEAR 7A




































35
Mr. Simon EARDLEY Emily Louise BROMLEY
Karen CARRILLO ZEPEDA
Anh Quynh DUONG
Abdulaziz Mohammed I. DAHLWY
Regina GÓMEZ TAGLE RAMÍREZ
Boi HO Nhi Que LUONG
Alan RAKHMAN Dung Hoang PHAM
Sophie Le SCHOEN Hyunwoo SO
Tuong Trieu THAI
Binh Gia VU (Fredy)
Khanh An Le TRAN
My Thao XA
Fucheng XU (Felix)
REIGATE GRAMMAR SCHOOL VIETNAM
Nguyen Khoa DAO


36
There are no shortcuts to any place worth going. Beverly Stills
YEAR 7B














































37
Mr. Robert MOORS Lien To Bao DANG Vy Ha DO
Eaindra Ayana GERRITS
Hadrien Edgar DUPASQUIER
Soham KAPOOR Anh Duc KIEU
Amanda Marcon LEE
Minh Anh Duc NGUYEN
Tadhg Vito MURPHY
Hieu Cong PHAM An Thanh NGUYEN
Tobias Vu Khue REICH
My Ha Do VU An Minh VU
Viet Quoc VU
Sun Gyu KIM
REIGATE GRAMMAR SCHOOL VIETNAM
David Karl Doan LARSSON


38
I think it’s possible for ordinary people to choose to be extraordinary. Elon Musk
YEAR 8A















































39
Sophie Suong CAREW-REID
Duong An DAM Comfort Yuliya Palestina Eastman DICKINSON
Anh My Ngoc KIM
Khoi Viet DO (James) Dong Gyun KIM
Eun Ryul KIM (Edward) Anh Minh LE Han Gia NGUYEN Chi Lan NGUYEN My Ha NGUYEN Danh The NGUYEN
Phuong Khanh Thi NGUYEN Seo Jun PARK
Anh Duc PHAM Hoang Tuan PHAM
Zion Gray (Zion) PAYAD Nam Bao Hoang PHAM Lan Phong VO
Victor Le THIBERT
REIGATE GRAMMAR SCHOOL VIETNAM
Mr. Preston DUKES


40
I find that the harder I work, the more luck I seem to have. Thomas Jefferson
YEAR 8B














































41
Ms. Kendall QUISENBERRY
Jong Oh BAE (Jimmy)
Minh Nhat DAO
Chi Hanh HA
Ha Khanh DO
Minh Hieu Gia HOANG Sunhyo KIM (Olivia)
Lam Dieu Tran LE
Seunggi LEE
Vy Lan Hoang LE
Ji Woo LIM Khanh Gia Le NGO (Tony)
An Chuc To NGUYEN
Samuel Bui SMITH
Anh Tue THAI Lam Tue TRAN Khanh Kieu VU REIGATE GRAMMAR SCHOOL VIETNAM
Minh Khoi NGUYEN


42
Genius is 10% inspiration, 90% perspiration. Thomas Edison
YEAR 9A









































43
Mr. Edward FORWARD
Byeongjun CHOI
Nam Tri DANG
Lucas Emanuel Montero De GRACIA
Linh Gia DAO
Hanna HERNANDEZ SILVA
Ki Min KIM
Tae Hwi MIN
Billy NGUYEN Anh Phuong NGUYEN
Don NGUYEN Lam Bao NGUYEN (Toto)
Nhu Uyen NGUYEN (Jessie)
Angela Mai ROBIJN
Van Thu TRAN Mai Ngoc TRUONG
Yen Ha NGUYEN
REIGATE GRAMMAR SCHOOL VIETNAM
Seok Hyun YEO
Motivation is what gets you started. Habit is what keeps you going.
 Jim Ryun
Jim Ryun

44
YEAR 9B


















































45
Mr. Ian STUCKEY Seoyeon CHO
Jun Woo HONG
Jihu KANG
Anh Hai Nguyen HUYNH
EunGyu KIM Gabin KIM
Seonyu KIM (Vivian)
Seung Jin LEE
Nam Nhat Dang LE
Hyeong Gyu LIM Anh Ha Tran NGUYEN
Chau Le NGUYEN
Nhu Quynh NGUYEN
Nam NGUYEN
Huy Gia PHAN
Nashom Begum SAYED
Yejin SHIN
William Minh Nhat Hoang TRINH
REIGATE GRAMMAR SCHOOL VIETNAM
Jia Le Melvin Tham Thai Du SIM


46
Success is the sum of small e orts, repeated. R. Collier
YEAR 10A


















































47
Ms. Huiyen ONG
Chau Hien Thi DINH
Minh Nhat DO
Alexandre Gabriel DUPASQUIER
Luong Anh DOAN
Anh Tu HA (Amanda)
Nghia Minh HOANG Jaewan JO
Anh Quoc KIEU
Sadhika KAPOOR
Hyeonsong KIM
Thu Minh Kieu LE
Pietro Marcon LEE
Linh Ha NGUYEN
Linh Bang Diem NGUYEN
Linh Ha PHAM Hyejin SHIN
Khoa Anh TO Tri Minh Do VU
REIGATE GRAMMAR SCHOOL VIETNAM
Tran Bao UONG
Lincoln


48
The best way to predict your future is to create it. Abraham
YEAR 10B




















































49
Mr. Joseph MARQUEZ
Ngan Kim Ngoc BACH
Yeonoh BAE
Xenne Thian GERRITS
Minkyu KWACK Rebecka Signe Tuyet LARSSON
Dang Minh XA
Anh Vu NGUYEN Alua RAKHMAN
Khanh Gia Pham LE Lam Ngoc Hoang LE Minh Hong LE
Tue Minh LE Linh Ha Vu NGUYEN Siha PARK
Ngoc Bao Pham TRAN
Anh Ha VU Kwonjin WOO (Bryan)
Mikayla Clara NAMORA
Martin RESTREPO ARANGO
REIGATE GRAMMAR SCHOOL VIETNAM
Minh Le PHAM


50
The future belongs to those who believe in the beauty of their dreams. Eleanor Roosevelt
YEAR 11A













































51
Quang Nhat DAO
Kangmin KIM
Hung Quoc LE (John)
Thao Nguyen LE
Chau Minh NGUYEN (Jane)
Luan Khang MAO
Khanh Nam Chinh NGUYEN
Nam Tue NGUYEN Nhan Dieu TANG (Jill)
Duong Hoang TRAN Duc Minh TRAN
Hung Le TRAN Viet Duc TRAN
Dieu Quang TRUONG
Sang Hyun YEO
Ngoc Khanh Nguyen VU
Anh Duc KIEU
Thu Minh DINH (Letter)
Huy Gia AU
REIGATE GRAMMAR SCHOOL VIETNAM
Mr. Sander ter MEULEN
You are braver than you believe, stronger than you seem and smarter than you think.

 A.A. Milne
A.A. Milne
52
YEAR 11B















































53
Mr. Ludovic PIROLLEY Anh Duy Dang KHUC
Du Khai DAM Khoi Minh DANG Ngoc Minh DO Anh Thuy DUONG (Annie)
Huyen Ngoc NGUYEN
Quan Hoang LE An Quoc NGUYEN Ha Minh NGUYEN Hieu Duc NGUYEN Minh Quang NGUYEN
Nam Hoang PHAM
Phuong Ha NGUYEN (Fu) Phuong Minh NGUYEN Sam NGUYEN
Triet Minh PHAM Serge Jan Endaya PILIIN
REIGATE GRAMMAR SCHOOL VIETNAM
Giang Huong TO Dung Quang TRAN (Lucas) Minh Anh TO
Learn from yesterday. Live for today. Hope for tomorrow. Albert Einstein


54
YEAR 11C











































55
Mr. Redhemer PAYAD Tobias Yule Washington DICKINSON
An Thanh DINH
Duc Ngoc LE
Ian KANG
Jongyun LEE (Yun)
Chaejung LEEM (Jung)
Chau Bao NGUYEN
Kiet Tuan NGUYEN (Samson)
Hanh Minh NGUYEN (Lucy)
Linh Ha NGUYEN (Jessica)
Linh Khanh NGUYEN (Linh)
Minh Tue NGUYEN
John Chloe NKWAYA (JC)
Nam Nhat NGUYEN
Chi Linh Nguyen PHAM (Evie)
Minh Nhat PHAN (Joey)
REIGATE GRAMMAR SCHOOL VIETNAM
Thy Khanh Do PHO (Tea) Thanh Chi UONG
The more that you read, the more things you will know, the more that you learn, the more places you’ll go.

 Dr. Seuss
Dr. Seuss
56
YEAR 11D




















57
Mr. Richard CROOK
Kien Chi Do DUONG Duong Dai HOANG Dung Tan NGUYEN
Nhan Tri NGUYEN Linh Bao NGUYEN (Stephanie)
Haeun PARK (Angella)
REIGATE GRAMMAR SCHOOL VIETNAM
Chau Minh PHAM Trang Hien Thi PHAN (Sylvia) Ngoc Minh PHUNG


58 Today a reader. Tomorrow a leader. Anonymous
YEAR 12A
































59
Ms. Elizabeth SCHULZE
Huy Dinh BUI Marisa Quynh Mai CRAFT
Yuvraj Singh DHAKA
Junhui GANG
Vu Kim DO
GaHyeon KIM (Grace)
Khanh Ngoc Vu NGUYEN (Katie)
Linh Gia NGUYEN
My An NGUYEN (Amy)
Uyen Hoang NGUYEN
Linh Thuy PHAM
Hosea Vu Kha REICH
Laura Elena Lomibao SANTOS
REIGATE GRAMMAR SCHOOL VIETNAM
Tran Bao TRUONG Phuc Gia TO
In a world where you can be anything, be kind.

 Jennifer Dukes Lee
Jennifer Dukes Lee
60
YEAR 12B






























61
Mr. Manrik THIARA
Seo-Hyun JOO Gyoungseo KIM (Sue)
Han Gia LE (Hayley)
Linh Khanh LE Ngoc Bao Do LUONG (Lilith)
Chaeeul MIN Minh Tan NGUYEN Khoi Danh NGUYEN
Linh Huong PHAM Minh Quang Nguyen PHAM
Nhi Yen Nguyen PHAM
Riley John SCHULZE
REIGATE GRAMMAR SCHOOL VIETNAM
Linh Thao TRAN Chau Minh Thien NGUYEN
None of us is as smart as all of us.
 Ken Blanchard
Ken Blanchard

62
YEAR 12C




































63
Ms. Binh Thi LINH Linh Gia DANG
My Ha Ngoc DO
Huy Quang HA (Hans)
Lam Khanh HOANG (Lou)
Quang Xuan MAI (Quang)
Duy Duc NGUYEN (Ben)
Hieu Trung NGUYEN
Son Minh Duc NGUYEN
Huy Nhat NGUYEN
Anh Minh PHAM Chau Bao PHAM (Molly)
Ngan Thu PHAN (Esther)
Giang Chau TRAN
Anh Viet TRAN Anh Bao TRINH (Claire)
REIGATE GRAMMAR SCHOOL VIETNAM
Khue Lam Dang VU Tam Bao DINH


64
have to be
to be
You
odd
No.1. Dr. Seuss
YEAR 13A


























65
Mr. James HOPKINSON
Jonghyun BEIK Anh Ha DAO (Lisa)
Dat Tien HA
Chi Lan Hoang LE
Linh Duy HA (Marlin)
Hanh Nguyen LE (Serina)
Tri Thanh LE Anh Duc NGUYEN
Hung Duc NGUYEN
Han Thu NGUYEN
Valentina Zoe DIAZ RODEA
REIGATE GRAMMAR SCHOOL VIETNAM
Minh Binh PHAM
OnceaReiga-tianForeveraReigatian

66
YEAR 13B




























67
Ms. Hien Thu Thi PHAN
Yena CHO Giang Hoang Trong DO Duc Anh Bui DOAN (Duck)
Nguyet Minh LE
Tuan Minh HOANG (Steve)
Tung Son Nguyen LE Duong Anh NGUYEN (Hazel)
Linh Ngoc NGUYEN (Essy) Naye KA
Seo-Jin JOO
REIGATE GRAMMAR SCHOOL VIETNAM
Cuong Hung TRAN Minh Ngoc TRAN Giao Quynh TRUONG
OnceaReiga-tianForeveraReigatian

68
YEAR 13C




























69
Mr. Andrew SILVANUS
Thien Anh CHU Long Vu DANG
Chaewon LEE (Jessica)
Khoi Tuan NGUYEN Linh Thuy LE
Lan Phi NGUYEN Tien Thuy NGUYEN Jinyong KU
An Thai Le PHAN (May)
Hieu Thanh PHAM
Hoan Tran PHAN
Rory Alistair THORNS
REIGATE GRAMMAR SCHOOL VIETNAM
Jieun WOO (Blaze)
OnceaReiga-tianForeveraReigatian

70













































































































































































































































































































































































































































































































































































































































































71


























































































































































































































































































































































































































































































72
Nursery Reception






76
YEAR 1








What a year of change! We started the year having a combined class of Year 1 and Reception students During this time you were caring towards the Reception students and modelled principled behaviour You have all changed so much this year. It's been a pleasure to be part of your learning journey. You showed great creativity and understanding in your Unit of Inquiry projects. For example in the model communities, animal habitats and story books you made. Your ability to count in many ways, to measure and organise data is equally impressive You are all becoming competent storytellers, builders, scientists and mathematicians! The way you have all matured, learning to work together and care for each other is a huge credit to each of you It was fantastic to watch your relationships with Year 11 ECA friends grow. All the best with your future learning





 Mr. Kris
Mr. Kris




77
YEAR 2i























































































Year 2I has had a fantastic year! Some of the highlights were out of class activities like our nature walk as we classified living and non-living things. Our practical learning on measurement included working in pairs to measure volume and working in groups to measure their heights in centimetres. They also loved the tug of war game as we learned about forces. The cross country race was also quite memorable! ass loves outdoor learning!











Year 2T Year 2T






79



























































































































































































































































































































































83
Secondary homeroom class pages


























































































































































































































































































































































































































































































84























































































94
Y E A R 1 0 A Y E A R 1 0 A
Year 10B Year 10B
























































































































































103 1 3 A











104










105 …
Teams pages


























































































103
PPREFECTS REFECTS team team
Year 13 : Thu Han NGUYEN, Seojin JOO, Hung Duc NGUYEN
Year 12 :Gyoungseo KIM, Hieu Trung



NGUYEN, Marisa CRAFT, My DO, Laura Elena Lomibao SANTOS, Chau PHAM, Lam Khanh HOANG, Seohyun JOO, Son Minh Duc NGUYEN
Year 11 : Phuong Minh NGUYEN, Linh Ha
NGUYEN, Chi Linh Nguyen PHAM, Anh DUONG, Hanh Minh NGUYEN
Year 10 : Anh Ha VU, Sadhika KAPOOR, Ngan Kim Ngoc BACH, Ngoc Bao Pham TRAN
107
" Bridging The Gap " - A charity event in collaboration with RGS UK




ECA























































































































































109
CA CTVITIE




CURRICULAR EXTRA ACTVITIES














113
ECA
Events



















































































































































111
































































































112
O 20







RT'S T'S T S DAY 22 Y
SPO 2022





















116
Sport's day '22




















117
INTERNATIONAL


DAY '22 INTERNATIONAL DAY '22
























R N A T I O N A L D A Y 2 0 2 2 R N A T I O N A L D A Y 2 0 2 2 N T E I N T E


























































































































Favorite avo ite o m e n t s r Cross Country ' 23





























C r o s s C o u n t r y ' 2 3
Bazaar W I N T E R
















R G S V !





































LUNAR BAZAAR '23 LUNAR BAZAAR '23










































































World Scholar's Cup


Ha Noi Round 2022



Team awards: Linh Bang Diem NGUYEN + Ngoc Bao Pham TRAN + Minh Nhat DO first place, senior division: Team challenge and team debate second place, senior division: collaborative writing champion team, senior division
Ha Noi Round 2023
Individual awards: Champion scholars

Minh Nhat DO - third place, senior division
Linh Bang Diem NGUYEN - second place, senior division Ngoc Bao Pham TRAN - first place, senior division
Team awards:
Nguyen Khoa DAO + Anh Minh VU - Super Junior division
First place: Overall
Second place: Team Challenge
Hieu Cong PHAM - Super Junior division

Second place: Overall
First place: Team Challenge
Nam NGUYEN + Khanh An Tran LE + My Thao XA - Junior division
Fifth place: Overall
Second place: Team Challenge
Individual awards:
Champion scholars: Super Junior division



Nguyen Khoa DAO, third place
Hieu Cong PHAM, first place
126
W
L D S C H O L A R ' S C U P
O R
2022 - 2023
2022 - 2023
This is RGSV Orchestra















The biggest paycheck: RESPECT

TEDxRGSV THE BIGGEST PAYCHECK: RESPECT

This is the first time TEDxRGSV is held offline after the pandemic Even though it was challenging for the Organizing Committee to set up everything from scratch, all efforts paid off
The core team with three members (Lou, Han Gia Le, and Trung Hieu Nguyen) started the brainstorming process way back in August 2022. Then more people joined along the way and formed the Organizing Committee as well as mentors. It was really a journey working together, creating such an event.

The event took place on 23/02/2023 in the RGSV gym and was a huge success with the speeches of four speakers: Lou, Tran, Tue Minh, Annie and Mr Simon, who helped the whole team turn TEDxRGSV’23 into reality



Special thanks to
Mr Simon Eardley
Ms. Jazmyn Rimington
Han Gia Le
Hieu Trung Nguyen
Lam Khanh Hoang (Lou)
Sadhika Kapoor
Le Hung Tran
Hung Duc Nguyen
Thao Nguyen Le
My An Nguyen
Bao Anh Trinh
Gahyeon Kim
Phuc Gia To

Linh Gia Dang
Linh Gia Nguyen
Lucas Lanouhe
Chau Bao Pham (Molly)
Linh Ha Nguyen Sam Nguyen
Chau Minh Thien Nguyen
Uyen Hoang Nguyen
Quang Xuan Mai
Tran Bao Truong
Minh Tue Nguyen
Anh Thuy Duong
Linh Ngoc Nguyen
Duong Anh Nguyen
128 TEDxRGSV '23
RG SV MODEL UNITED NATIONS




























































































































The Model United Nations (MUN) is an educational event, organised by schools around the world as a way for students to engage in topics of global significance as a delegate representing a country or region. Some students may also chair (lead) a committee, where they facilitate delegates through the process of drafting, debating, amending and passing resolutions. In committees such as the Security Council, General Assembly, or Human Rights Council, students debate, collaborate and try to find solutions for issues of concern to us all. This year, students participated in events at UNIS (both the November and the March conferences) and at BIS (March).

In the most recent MUN ECA term, the core organising team for RGSV MUN is taking the time to get our own event up and running again after a hiatus following the COVID years. It will be an exciting time and the team is already starting to create their plan for next school year's event.






































129
Mr David and Ms Sandra RGCS MUN Directors



TRICK TREAT OR R


















































































































































131











133
swimming











134
SWIM GALA













135
Subject Areas Specialist





















































































133

























SECONDARY EAL DEPARTMENT



The EAL & English Skills Development (ESD) team works to build the confidence of all of our Year 7, 8, & 9 learners to fully express their ideas through writing and speaking We find engaging ways to get the best out of students & encourage them to improve further. Our ESD students develop their spoken fluency skills by using tools like News Bites, Event Checks & Opinion Pieces.

The EAL team supports the language goals of students on the EAL Register. We work closely with Science and Humanities colleagues to improve outcomes in the teaching and learning process



English Skills Development English Skills Development
EAL & Subject Teacher Collaborations EAL & Subject Teacher Collaborations


142






Geography!




















145

146

































147Computing UNIS Robocoders Network Topologies Computational Thinking


149



Secondary Vietnamese Language and Literature




























..Chưa chữ viết đã vẹn tròn tiếng nói
Vầng trăng cao đêm cá lặn sao mờ
Ôi tiếng Việt như bùn và như lụa
Óng tre ngà và mềm mại như tơ.
Tiếng tha thiết, nói thường nghe như hát
Kể mọi điều bằng ríu rít âm thanh
Như gió nước không thể nào nắm bắt
Dấu huyền trầm, dấu ngã chênh vênh.
Dấu hỏi dựng suốt ngàn đời lửa cháy
Một tiếng vườn rợp bóng lá cành vươn
Nghe mát lịm ở đầu môi tiếng suối
Tiếng heo may gợi nhớ những con đường…. (Tiếng Việt - Lưu Quang Vũ)
Vietnamese study
153
Early years Music

Ms. Jessanin De La Rosa Ms. Jessanin De La Rosa
It has been an absolute pleasure teaching music to our early years students this year. Watching them discover and explore the world of music has been a true delight
Throughout the year, we have sung, danced, and played a variety of instruments, from rhythm sticks to xylophones. We have learned about different styles of music, from classical to folk, and even tried our hand at composing our own songs.

What has been most impressive is the enthusiasm and creativity our students have brought to each lesson. Their joyous energy and eagerness to learn has been truly inspiring. I am grateful for the opportunity to teach these young musicians here at RGSV

154
IGCSE and DP Music


Mr. Daniel Hewitt Mr. Daniel Hewitt
The upper secondary music programs involve composing, arranging and performing music.




The courses provide a fantastic preuniversity foundation through research, analysis and subsequent creating and performing. Highlights include music from Beethoven, Joe Hishaishi and even popular repertoire from Elton John to Adele.


Diploma students have performed several concerts throughout the year, sharing performance and personal compositions in various styles with impressed audiences.
Our Diploma and IGCSE cohorts have submitted extensive portfolios of their work to be considered for final assessment over the summer



All the very best for your results this year!

155
Year 4, 5 & 6 Music
Mr. ManuelZazueta Mr. ManuelZazueta
"Movement is the basis of all artistic manifestations"



Music education through Dalcroze



Eurhythmics emphasizes the integration of movement, rhythm, and ear training to develop a holistic and creative understanding of music.



- Émile Jaques-Dalcroze
Throughout the y ear, we have been exploring music through various activities that engage our bodies, minds, and emotions developing our sense of pulse, tempo, and phrasing. We have also been practising movement improvisation and gesture-based expression to explore music's emotional and narrative dimensions.

Do you think the Dalcroze method has been a fun and engaging way to learn about music? We've had some great moments. I hope in the future you remember your music lesson whenever you listen to music and feel like moving!

156
Year 7 & 8 Music

Intro Art Intro Art
Nguyen Thien Minh Nguyen Thien Minh Nguyen Ngoc Huy Nguyen Ngoc Huy Bui Ha Mien
Nourish the mind and ignite a lifetime of passion




Throughout the year, students have been guided by our skilled instrument instructors, who have helped them learn the technical and musical aspects of playing these beautiful instruments.
Students chose between Cello and V iolin at the beginning of the year and by December were playing as a group! We hope that after this experience they continue playing this or any other instrument so that music can always be a part of their life.




Learning about these instruments has helped students understand how music is produced, composed and interpreted. They train their inner ear, leadership abilities and teamwork skills.

157
Bui Ha Mien
Mai Xuân Hải Mai Xuân Hải
Violin instructors Violin
Cello instructor Cello instructor Coordinator
RGSV Symphony Orchestra
Manuel Zazueta Manuel Zazueta
Mai Xuân Hải Mai Xuân Hải
Concertmasters Concertmasters
Linh Thuy Pham Linh Thuy Pham
Nam Nhat Nguyen Nam Nhat Nguyen
Nourish the mind and ignite a lifetime of passion



Concerts are but a small part of the work we do in the RGSVSO. Our mission is to nurture our student’s passion for music, enabling them to play great works of art in a prestigious and achieving ensemble.


Our talented gro up of young and dedicated musicians constitute the first Symphonic Orchestra in an International or Local school in Vietnam!




Learning about these instruments has helped students understand how music is produced, composed and interpreted. They train their inner ear, leadership abilities and teamwork skills.

158
Assistant
Assistant
Principal Conductor Principal Conductor
conductor
conductor
Music Year 9

Manuel Zazueta Manuel Zazueta
Learning music through singing and Dalcroze Eurhythmics
In Year 9, students learned music through Dalcroze eurhythmics, a unique method using movement and physical expression to develop their sense of musicality and teamwork skills





They also participated in choir practice, where they developed their vocal technique, learned to sing in harmony , and gained confidence performing in front of others.
The Year 9 music program was a great success, and we are proud of their hard work and dedication to musical growth.




159
Prep PHE
















160
secondary PHE












Theory of Knowledge














































































163
Experiments



















164 S C I E N C E I S L I K E M A G I C . . . B U T R E A L !
STEM week challenge MAD Science Teachers Inquiry process
EXPLOSIVE
Group 4 Projects






Is there a single "scientific method" ?















165
IBDP Internal assessment T H E I M P O R T A N T T H I N G I S T O N E V E R S T O P Q U E S T I O N I N G
Creativity, Activity, Service (CAS) is one of the three essential elements that every student must complete as part of the Diploma Programme (DP).
Here are some examples of students’ achievements.
Creativity Activity Service
Performing at the Winter Bazaar

Hiking in Bali

First aid training

Quang Tri was one of the most damaged areas during and after the war. Even though the war ended almost 50 years ago, Agent Orange and landmines are still haunting their lives every day. People here are living in extremely di cult conditions. Therefore, our CAS project was founded to solve these problems by donating compassion houses. 30 houses have been donated so far. However, many families still skip meals or have meals with insu cient nutrients. This leads to kids su ering from malnutrition. We decided to add this urgent problem to our objectives. Immediately, we met with nutrition experts and found that the most suitable solution for them is to add soy milk to their diets. After all, HYCS desires to inspire the young generation to give more than take. A community where people actually put in their hearts, their e orts towards the same goal of improving the lives of the unfortunate.

166
Students from Reigate Grammar School Vietnam achieve top results in Outstanding Cambridge Learner Awards
Five students from Reigate Grammar School Vietnam received the prestigious awards from Cambridge Assessment International Education to acknowledge their outstanding performance in the June 2022 Cambridge examination series

The Outstanding Cambridge Learner Awards programme celebrates the success of learners taking Cambridge examinations in over 40 countries around the world. Cambridge places learners at the centre of their internat ional education programmes and qualifications which are inspired by the best in educational thinking.
The following students at Reigate Grammar School Vietnam received Top in the Countr y awards:
Syllabus
Combined Science
Combined Science
Computer Science
Co-Ordinated Sciences (Double Award)
Student name
Gahyeon KIM
Huy Nhat NGUYEN
Son Minh Duc NGUYEN
Uyen Hoang NGUYEN
Information & Communication Technolog y Hieu Trung NGUYEN
World rank
Second place
167
W t
In the picture, from the left: Mr Colin, Son, Gahyeon, Uyen, Huy, Hieu, Mr Patrick

















































































165



















































































































































166

170

171



172



173


174


175



176



177

178

179

180

181

































 Mr Simon
Mr Simon
























































































































































































































































































































 John Wooden
John Wooden







































 Albert Einstein
Albert Einstein




























































 Oprah Winfrey
Oprah Winfrey
































































































































































 Jim Ryun
Jim Ryun




























































































































 A.A. Milne
A.A. Milne





















































 Dr. Seuss
Dr. Seuss





























 Jennifer Dukes Lee
Jennifer Dukes Lee















 Ken Blanchard
Ken Blanchard








































































































































































































































































































































































































































































































































































































































































































































 Mr. Kris
Mr. Kris